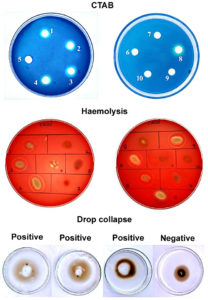

ISSN: 0973-7510
E-ISSN: 2581-690X
Marine oil pollution is a persistent environmental hazard that necessitates eco-compatible remediation strategies. This study reports the isolation and identification of biosurfactant-producing bacterial strains from oil-contaminated seawater collected from Ennore Harbor, Chennai, India. A total of 21 morphologically distinct isolates were obtained and evaluated for their biosurfactant-producing abilities using CTAB (Cetyl Tri Ammonium Bromide) agar, hemolysis, drop collapse, oil spreading, and emulsification index (E24) assays. Among the isolates, Bacillus cereus Is15 exhibited the highest and most consistent biosurfactant activity. Molecular identification via 16S rRNA sequencing revealed Is15 as Bacillus cereus Is15. Optimization studies indicated that peptone and glucose, at pH 7 and 37 °C, significantly enhanced the biosurfactant yield (0.120 g) and crude oil degradation (1.084 g). GC-MS (Gas Chromatography-Mass Spectrometry) analysis indicated the presence of compounds with surface-active properties, including isopropyl myristate and tetradecanoic acid. The application of the biosurfactant in a laboratory-scale oil degradation assay mimicking marine conditions resulted in a substantial reduction in total petroleum hydrocarbons (1.186 g), comparable to that of sodium dodecyl sulfate (SDS; 1.512 g). These findings highlight the potential of B. cereus Is15-derived biosurfactants as efficient and environmentally sustainable agents for marine oil bioremediation.
Bacillus cereus, Biosurfactant, Bioremediation, Marine Pollution, GC-MS Analysis
Petroleum hydrocarbon pollution, which primarily results from marine transport, oil drilling, and accidental spills, poses a persistent ecological hazard to aquatic environments. Crude oil and its derivatives contain toxic compounds that adversely affect marine biodiversity, disrupt ecosystem services, and accumulate in the food web, posing long-term environmental and health risks.1 Conventional physicochemical methods used for treating oil-polluted water, such as skimming, dispersants, and incineration, often underperform due to high cost, inefficiency at low pollutant concentrations, and the generation of secondary pollutants.2 In contrast, bioremediation, particularly the use of biosurfactant-producing microorganisms, offers an environmentally friendly and cost-effective alternative. Biosurfactants are amphiphilic compounds synthesized by various bacterial genera that are capable of reducing interfacial and surface tension, thus enhancing the bioavailability and solubility of hydrophobic hydrocarbons.3 Marine bacteria, which have evolved in hydrocarbon-rich habitats, represent a valuable reservoir of biosurfactant-producing strains with high tolerance to salinity, pressure, and temperature fluctuations.4
This study aimed to isolate and identify bacterial strains capable of producing biosurfactants from oil-contaminated seawater obtained from Ennore Harbor, an industrial region in Chennai, India. The selected isolates were subjected to comprehensive screening assays, and the optimal production conditions were investigated using various carbon and nitrogen sources, pH levels, and temperatures. The biosurfactant yield and its efficacy in degrading crude oil were evaluated, followed by its application in simulated marine oil spill conditions. The results of this study underscore the potential of marine-derived biosurfactants as sustainable agents for the bioremediation of oil-polluted marine ecosystems.
Sample collection
Ten marine water samples were collected from hydrocarbon-contaminated sites within the Ennore Harbor, located along the Coromandel Coast in Chennai, Tamil Nadu, India (13.252851°N, 80.326744°E). Ennore Harbor is a major industrial maritime zone that experiences chronic petroleum pollution due to discharge from nearby petrochemical complexes, power plants, and shipping activities. Samples were collected aseptically from visibly oil-contaminated surface water in sterile polyethylene bags. Each bag was appropriately labelled with the site coordinates and collection date. All samples were transported immediately under cold conditions (4 °C) to the laboratory and processed within 24 h for microbiological analysis.
Enumeration of Hydrocarbon Degrading Bacteria (HDB)
The abundance of HDB in marine water samples was determined using a selective enrichment approach. Samples were serially diluted in sterile NaCl (0.85% w/v). From each dilution, 0.1 mL was spread onto sterile Bushnell Haas Agar (BHA) plates, which were pre-supplemented with 100 µL of sterile crude oil to serve as the exclusive carbon supplement. Crude oil was sourced from Chennai Harbor, filtered through a 0.45 µm membrane to ensure sterility, and stored in sterile bottles until use. The inoculated plates were aerobically incubated for 7 days at 25 °C. Following incubation, bacterial colonies that grew on the hydrocarbon-supplemented medium were counted, and the HDB population was expressed as CFU/mL-1.5
Screening of biosurfactant production by HDB
All HDB were qualitatively screened for biosurfactant production using multiple phenotypic assays. These methods detect surface-active compounds through distinct physical and biochemical interactions.
Blue agar plate assay
The presence of anionic biosurfactants was measured using the blue agar plate assay described by Tahzibi et al.6 The screening medium consisted of basal agar supplemented with CTAB and methylene blue, adjusted to pH 7.0 and autoclaved. After solidification, 6.5 mm diameter wells were aseptically bored into the solidified agar. Culture supernatant (100 µL) from overnight-grown bacterial isolates were aliquoted into each well. The plates were incubated for 48 h at 37 °C. The development of blue halos surrounding the wells indicated the presence of anionic biosurfactants that interacted with CTAB and methylene blue to form a visible complex.
Hemolysis on Blood Agar (BA)
The biosurfactant was further evaluated based on the ability of the isolates to lyse erythrocytes using a blood agar assay as previously described.7 Freshly prepared BA plates with defibrinated sheep blood (5% v/v) were used as the screening medium. Each bacterial isolate was spot-inoculated onto the surface of plates under sterile conditions. The plates were incubated for 24-48 h at 37 °C. Following incubation, the appearance of hemolytic zones surrounding the bacterial colonies was examined. The observation of a clear or partially clear halo indicated hemolytic activity, suggesting biosurfactant production due to the disruption of red blood cell membranes.
Drop collapse assay
This assay was used to assess the surface-active properties of the biosurfactants present in the culture supernatants as previously described by Rani et al.8 A sterile 96-well polystyrene microplate lid was used as the testing surface. Each well was pre-coated with 2 µL of crude oil and allowed to equilibrate at room temperature (approximately 22 °C) for 24 h to ensure uniform spreading. Subsequently, 5 µL of clarified supernatant from each isolate was gently dispensed into the focus of the oil-coated wells. The wells were visually examined after 1-2 min. A flattened or collapsed drop indicated a reduced surface tension and was recorded as a positive result for the biosurfactant. In contrast, the retention of a rounded drop indicated a negative result.
Oil spreading assay
The experiment was performed to assess the biosurfactant activity of the bacterial isolates, following the process described by Maneerat et al.9 20 mL of distilled H2O was pipetted out into the center of a sterile petri dish, and 20 µL of crude oil was gently layered on the water surface to form a uniform oil film. Subsequently, 10 µL of the culture supernatant was carefully added to the center of the oil layer. The presence of the biosurfactant led to a reduction in the surface tension, causing the oil to move aside and resulting in the formation of a clear zone. The diameter of the zone (in mm) served as evidence of biosurfactant activity. A control consisting of culture medium without biosurfactants was included for comparative evaluation.
Emulsification Index Assay (E24)
The emulsifying ability of the biosurfactants was determined using the emulsification index technique described by Maneerat et al.9 In this assay, 4 mL of the supernatant was mixed with 3 mL of crude oil in a sterile test tube. The contents were vortexed vigorously for 2 min to promote thorough mixing and emulsion formation. The test tubes were kept undisturbed at ambient temperature for 24 hr. The height of the resulting emulsion layer was measured and the percentage of the total liquid column height was calculated. A higher E24 value indicates greater emulsifying capacity of the biosurfactant. A control sample in which distilled water replaced the supernatant was included to determine the baseline emulsification.
Biosurfactant production, extraction, and quantification
Bacterial isolates, Is4, Is15 and Is18, which tested positive in all preliminary biosurfactant screening assays, were selected for production studies. Each isolate was inoculated into 100 mL of sterile Bushnell Haas Broth (BHB) supplemented with 1 g of sterilized crude oil as the sole carbon supplement. Cultures were incubated at a temperature of 30 °C for 7 days under shaking at 120 rpm to facilitate hydrocarbon degradation and biosurfactant secretion. Following incubation, the culture broth was centrifuged to remove the bacterial cells, and the resulting supernatant was used for gravimetric oil degradation analysis and biosurfactant extraction. Residual crude oil was extracted using diethyl ether, and the amount of undegraded oil was quantified by weighing after solvent evaporation. Degraded oil was calculated as follows.10
Crude Oil Degradation (g) = Initial Oil Weight – Residual Oil Weight
The same supernatant was used to recover the biosurfactant via acid precipitation. The pH was adjusted to 2.0 using 11.5 N HCl and incubated overnight at 4 °C. The extracted biosurfactant was obtained from the precipitate using a 2:1 (v/v) CHCL3-CH3OH mixture. The organic phase was separated and evaporated in a fume hood, and the dried biosurfactant was weighed. The weight of the recovered biosurfactant was recorded in grams. These values were used to assess the biosurfactant yield of each isolate under standard production conditions.11
Potential isolate identification
Identification of the potential isolate, Is15, at the species level was performed using 16S rRNA gene sequencing. Genomic DNA was extracted from Is15, and its quality was confirmed by the presence of a distinct high-molecular-weight band on a 1.0% agarose gel. Amplification of the 16S rRNA gene was performed with 16S rRNA-F (5′-AGAGTTTGATCCTGGCTCAG-3′) and 16S rRNA-R (5′-TACGGTTACCTTGTTAC GACTT-3′), primers resulting in a single, discrete amplicon of approximately 1500 bp. The PCR product was purified to remove any residual contaminants and subjected to bidirectional sequencing on an ABI 3730xl Genetic Analyzer with BDT v3.1 Cycle Sequencing Kit. Forward and reverse sequences were assembled to generate a consensus sequence using aligner software.12 The resulting 16S rRNA gene sequence was queried against the NCBI GenBank ‘nr’(non-redundant protein) database using BLAST, and the top ten hits based on maximum identity were aligned using ClustalW. To determine the evolutionary relationship, a phylogenetic tree along with a distance matrix was constructed using the neighbor-joining approach in MEGA 11 version.13
Optimization of biosurfactant production
To enhance biosurfactant yield and hydrocarbon degradation, the most promising bacterial isolate, Bacillus cereus Is15 was optimized under varying nutritional and environmental conditions. BHB supplemented with crude oil (1 g/100 mL) served as the basal production medium for all experiments. Each condition was tested in triplicate under gentle shaking for 7 days at 120 rpm at 30 °C. The combination of pH, temperature, and carbon and nitrogen sources that yields the maximum biosurfactant concentration and oil degradation efficiency is considered optimal for large-scale biosurfactant production.14
Effect of pH
To assess the effect of pH on biosurfactant production, the pH of the medium was adjusted to 6.0, 7.0, 8.0, 9.0, and 10.0 prior to inoculation. Cultures were incubated under standard conditions, and both the biosurfactant yield and crude oil degradation were determined at the end of the incubation.
Effect of temperature
Temperature optimization was carried out by incubating inoculated flasks at 17 °C, 27 °C, 37 °C, and 47 °C. After seven days, the samples were analyzed for residual oil and biosurfactant concentrations to identify the optimal temperature for metabolite production.
Effect of carbon sources
The influence of various carbon sources, such as glucose, fructose, lactose, sucrose, and dextrose, was evaluated by supplementing the production medium with these individually along with crude oil. After 7 days of incubation, oil degradation and biosurfactant yield were assessed to identify the most efficient carbon substrate.
Effect of Nitrogen sources
To optimize the nitrogen source, different organic and inorganic nitrogen supplements including casein, peptone, beef extract, yeast extract, and urea were added to the production medium at equivalent nitrogen concentrations. Following incubation, the residual crude oil and biosurfactant yield were measured gravimetrically to evaluate the influence of each nitrogen source.
Gas Chromatography-Mass Spectrometry (GC-MS) Analysis of Biosurfactant
The chemical composition of the biosurfactant produced by Bacillus cereus Is15 was determined using GC-MS. The biosurfactant extract was subjected to GC-MS analysis on an Agilent GC system 7890B coupled with an MSD 5977A detector using a HP-5MS capillary column with an ID of 30 x 0.25 mm and 0.25 µm film thickness. The gas chromatography oven was programmed to begin at 60 °C with an initial hold of 5 min, then increase at a rate of 8 °C/min until it reached 280 °C, where it was held for 37 min. Helium was used as the carrier gas and flowed at a constant rate of 1.0 mL/min. The injector temperature was set to 300 °C, and 1 µL of the sample was introduced in splitless mode. For mass spectrometry detection, the interface and ion source temperatures were maintained at 310 °C and 230 °C, respectively. Spectra were acquired in electron ionization (EI) mode at 70 eV. Component identification was performed by matching the acquired spectra with entries in the NIST 20 mass spectral database.15
Biosurfactant-mediated oil removal from marine water
The effectiveness of the biosurfactant extracted from Bacillus cereus Is15 in removing crude oil was evaluated under controlled laboratory conditions using artificially contaminated seawater. The clean marine sand was first sieved and evenly distributed into three separate plastic containers (100 g per container), labelled C1, C2, and C3. Crude oil (10 g) was added to 100 mL of sterile marine water in each container to simulate oil spill conditions, and the mixture was allowed to equilibrate for 10-12 days at RT. After the contamination period, 500 mg of purified biosurfactant was added to container C2, and 10 mL of 10% SDS solution was added to container C3. Container C1 served as an untreated control. All the containers were gently agitated to ensure uniform mixing and left undisturbed for 24 h.
To quantify the residual oil content, the total petroleum hydrocarbons (TPH) were measured using the n-hexane extraction method. A 100 g sample of the water-sand mixture was combined with 200 mL of distilled hydrogen peroxide (H2O2), acidified with hydrochloric acid (HCl), and then extracted using n-hexane, 100 mL. The organic layer holding the oil was separated through a separating funnel and dried in a hot air oven at 103 °C. The extracted oil was weighed using the gravimetric method, and the TPH value was calculated using the following equation:
TPH (g/100 g) = W2 – W1
where:
W1 = weight of empty dish
W2 = weight of dish after oil extraction and drying, respectively.
The efficiency of oil removal was compared across the treatments to evaluate the practical applicability of the biosurfactant in marine oil spill mitigation.
Statistical analysis
All experiments were conducted in triplicate, and data were expressed as mean ± standard deviation (SD). Statistical comparisons among groups (biosurfactant, SDS, and control) were performed using one-way analysis of variance (ANOVA), followed by Tukey’s post-hoc test. Statistical significance was set at p < 0.05. Statistical analyses were performed using the IBM SPSS software version 22.
Isolation and enumeration of hydrocarbon-degrading bacterial isolates
Ten marine water samples collected from oil-contaminated locations in the Ennore Harbor were subjected to microbial analyses. The HDB population was determined by plating serially diluted marine water samples on BHA supplemented with crude oil. After 7 days incubation period, visible bacterial growth was observed on all plates, indicating the capacity of certain colonies to utilize crude oil as their sole carbon source. A total of 21 morphologically discrete bacterial isolates were obtained, reflecting the diversity of hydrocarbon-degrading heterotrophs present in the samples. Each isolate was preserved and further evaluated for biosurfactant synthesis potential.
Screening of biosurfactant producing isolates
All 21 bacterial isolates capable of degrading hydrocarbons were assessed for biosurfactant production using a set of qualitative screening assays, including the blue agar plate method, blood agar hemolysis, drop collapse, oil spreading, and emulsification index (E24). Of the 21 isolates, three (Is4, Is15, and Is18) showed consistently positive results across all five screening methods (Table 1). These isolates exhibited distinct blue halos on CTAB-methylene blue agar, clear zones of hemolysis on blood agar, significant oil displacement in the oil spreading assay, drop collapse behavior, and EI values > 50%, indicating strong biosurfactant activity. These three high-performance isolates were selected for biosurfactant production and further characterization. Figure 1 shows the representative results of the biosurfactant screening of selected isolates among the 21 tested isolates.
Table (1):
Preliminary screening of biosurfactant-producing bacterial isolates
Isolate |
CTAB |
Haemolytic activity |
Oil Spreading |
Drop Collapse |
Emulsification Index |
|---|---|---|---|---|---|
Is1 |
+ |
+ |
+ |
– |
++ |
Is2 |
+ |
– |
– |
+ |
– |
Is3 |
+ |
+ |
+ |
– |
++ |
Is4 |
+ |
+ |
+ |
+ |
+++ |
Is5 |
– |
– |
– |
– |
+++ |
Is6 |
– |
+ |
+ |
+ |
++ |
Is7 |
– |
– |
– |
– |
– |
Is8 |
+ |
+ |
+ |
– |
++ |
Is9 |
– |
+ |
+ |
– |
– |
Is10 |
– |
+ |
+ |
– |
– |
Is11 |
– |
– |
+ |
– |
++ |
Is12 |
– |
– |
+ |
– |
– |
Is13 |
– |
+ |
+ |
– |
– |
Is14 |
+ |
– |
+ |
– |
– |
Is15 |
+ |
+ |
+ |
+ |
+++ |
Is16 |
– |
+ |
– |
– |
+ |
Is17 |
+ |
– |
+ |
– |
– |
Is18 |
+ |
+ |
+ |
+ |
+++ |
Is19 |
– |
+ |
– |
– |
– |
Is20 |
+ |
+ |
– |
– |
– |
Is21 |
+ |
+ |
+ |
– |
– |
Figure 1. Representative images of biosurfactant screening assays (CTAB, haemolysis and drop collapse) for selected bacterial isolates
Biosurfactant production and crude oil degradation
Three selected isolates (Is4, Is15, and Is18) were cultured in BHB supplemented with crude oil to evaluate biosurfactant production under optimized conditions. After a 7-day period, both the residual oil and biosurfactant yields were quantified. Is15 exhibited the highest crude oil degradation, with 0.643 g of degraded oil and a corresponding biosurfactant yield of 0.091 g. Is4 degraded 0.614 g of oil and produced 0.075 g of biosurfactant. Is18 degraded 0.311 g of crude oil with a biosurfactant yield of 0.074 g (Table 2). These results demonstrate that all three isolates possess effective oil-degrading and biosurfactant-producing capabilities, with Is15 showing the highest overall performance.
Table (2):
Crude oil degradation and biosurfactant production by potential isolates
No. |
Isolate |
Initial Oil Volume (g) |
Oil Degradation (g) |
Biosurfactant Yield (g) |
|---|---|---|---|---|
1. |
Is4 |
2.5 |
0.614 |
0.075 |
2. |
Is15 |
2.5 |
0.643 |
0.091 |
3. |
Is18 |
2.5 |
0.311 |
0.074 |
Identification of the potential crude oil-degrading and biosurfactant-producing isolate Is15
Molecular identification of isolate Is15 was performed by sequencing the 16S rRNA gene. High-quality genomic DNA was isolated, and a fragment approximately 1500 bp in length, corresponding to the 16S rRNA gene, was successfully amplified and sequenced. The consensus sequence was generated by aligning forward and reverse reads, and BLAST analysis against the NCBI database revealed 99.93% identity with Bacillus cereus strain IHB B 6826 (Accession No. KF668460.1). Other closely related strains included Bacillus cereus ST06 (MH475925.1), Bacillus paramycoides IBPHC1 (PQ008468.1), and Bacillus sp. ST-R5 (MFF99669.1) showed 99.87% sequence similarity. Figure 2 shows the top hits demonstrating close identity to Bacillus cereus, confirming the species-level identification. Phylogenetic analysis using the Maximum Likelihood method and the Tamura-Nei model confirmed a close evolutionary relationship between Is15 and Bacillus cereus strains, clustering distinctly within the B. cereus clade. Evolutionary divergence was minimal, with pairwise distance values ranging from 0.000 to 0.003, supporting a high degree of sequence conservation. The sequence was submitted to the NCBI database and assigned the accession number PV926415. Thus, isolate Is15 was identified as Bacillus cereus Is15, suggesting its potential role in crude oil degradation and biosurfactant production based on the known functional traits of this species.
Figure 2. Phylogenetic tree showing evolutionary relationship of the isolate with closely related Bacillus strains
Optimization of biosurfactant production parameters
The effects of key physicochemical and nutritional parameters on biosurfactant production and crude oil degradation were investigated using the best-performing bacterial isolate, Bacillus cereus Is15. Among the tested pH values (6.0-10.0), the maximum biosurfactant production (0.087 g) and oil degradation (0.644 g) were observed at pH 7.0. Both acidic and alkaline conditions reduced biosurfactant yield and degradation efficiency. The effect of varying pH on oil degradation and biosurfactant yield is shown in Figure 3, showing that optimal production was observed at pH 7. Temperature also plays a significant role in the biosynthesis of biosurfactants. As illustrated in Figure 4, biosurfactant production was highest at 37 °C, indicating the temperature sensitivity of the isolates. Incubation at 37 °C yielded the maximum biosurfactant concentration (0.056 g) and crude oil degradation (0.481 g). However, at both lower (17 °C and 27 °C) and higher (47 °C) temperatures, there was a notable reduction in both parameters. Oil degradation declined to 0.290 g and 0.382 g at 17 °C and 27 °C, respectively, while biosurfactant yields were limited to 0.031 g and 0.041 g. At 47 °C, a further decline was observed, with oil degradation and biosurfactant yield dropping to 0.126 g and 0.019 g, respectively. These findings suggest that temperatures deviating from the mesophilic optimum negatively affect the enzymatic activity and microbial performance.
Among the carbon sources tested, glucose resulted in the highest biosurfactant production (0.089 g) and oil degradation (0.589 g). Lactose and fructose had moderate yields, whereas sucrose and dextrose produced poor yields. The influence of the carbon source on biosurfactant synthesis is depicted in Figure 5, showing that glucose provided the highest yield. Of the five nitrogen sources examined, peptone was the most effective with a biosurfactant yield of 0.096 g and oil degradation of 0.724 g. Casein also supported substantial production, whereas beef extract and urea were the least effective. Among the nitrogen sources tested (Figure 6), peptone resulted in maximum oil degradation and biosurfactant yield. The combination of glucose and peptone at pH 7.0 and 37 °C produced the highest biosurfactant yield (0.120 g) and maximum oil degradation (1.084 g), suggesting that these parameters complement each other in enhancing metabolic activity.
Figure 5. Effect of various carbon substrates on biosurfactant yield and hydrocarbon degradation efficiency of Bacillus cereus
Figure 6. Effect of various nitrogen substrates on biosurfactant yield and hydrocarbon degradation efficiency of Bacillus cereus
GC-MS analysis of biosurfactant
The GC-MS analysis of the biosurfactant extracted from Bacillus cereus Is15 illustrated the presence of 20 distinct compounds with varying structural classes and functional groups (Figure 7 and Table 3). This analysis revealed a diverse range of metabolites that contributed to the amphiphilic nature of the biosurfactant. The major component was isopropyl myristate (43.97%), a fatty acid ester known for its surfactant and emulsifying properties. This was followed by tetradecanoic acid (13.40%) and 3-heptadecanol (6.92%), which are long-chain fatty acid derivatives with surface-active potential. A series of aliphatic hydrocarbons was also identified, including heptadecane (2.29%), pentacosane (2.24%), hexadecane (1.13%), and heptacosane (0.36%), which likely contributed to the hydrophobic interactions essential for emulsification. Additionally, aromatic and phenolic compounds such as 2,4-di-tert-butylphenol (0.94%), 1,2-benzenedicarboxylic acid, and bis (2-methylpropyl) ester (0.91%) were present, suggesting potential antimicrobial or antioxidant functions. Collectively, the composition of esters, fatty acids, hydrocarbons, alcohols, and phenolics supports the multifunctional properties of biosurfactants and their applicability in pharmaceutical and environmental remediation contexts.
Table (3):
GC-MS analysis of biosurfactant extract
No. |
Compound Name |
RT (min) |
Area (%) |
Molecular Formula |
|---|---|---|---|---|
1 |
Undecane, 4-methyl- |
7.006 |
0.39 |
C12H26 |
2 |
Hexadecane |
10.291 |
1.13 |
C16H34 |
3 |
Maleamic acid |
10.487 |
0.32 |
C4H7NO3 |
4 |
Heneicosane |
10.921 |
0.86 |
C21H44 |
5 |
Pentacosane |
13.131 |
2.24 |
C25H52 |
6 |
Hexadecane, 2,6,10,14-tetramethyl- |
13.240 |
0.37 |
C20H42 |
7 |
2,4-Di-tert-butylphenol |
13.412 |
0.94 |
C14H22O |
8 |
Pentacosane |
13.677 |
1.44 |
C25H52 |
9 |
10-Methylnonadecane |
13.801 |
0.39 |
C20H42 |
10 |
1-Phenanthrenecarboxylic acid, 7-ethenyl- |
13.914 |
0.36 |
C18H22O2 |
11 |
Tridecane, 1-iodo- |
15.280 |
0.35 |
C13H27I |
12 |
Tetrapentacontane, 1,54-dibromo- |
15.360 |
1.04 |
C54H110Br2 |
13 |
Heptadecane |
15.629 |
2.29 |
C17H36 |
14 |
Heneicosane |
15.728 |
0.61 |
C21H44 |
15 |
Heptacosane |
15.880 |
0.36 |
C27H56 |
16 |
Tetradecane, 3-methyl- |
16.103 |
1.71 |
C15H32 |
17 |
Tetradecanoic acid |
16.277 |
13.40 |
C14H28O2 |
18 |
3-Heptadecanol |
16.663 |
6.92 |
C17H36O |
19 |
Isopropyl myristate |
16.860 |
43.97 |
C17H34O2 |
20 |
Oxalic acid, 6-ethyloct-3-ylheptyl ester |
17.100 |
0.46 |
C15H26O4 |
Application of biosurfactant for crude oil degradation in a controlled seawater environment
The crude-oil removal efficiency of the extracted biosurfactant was evaluated in oil-contaminated marine water. Three treatment conditions were compared: untreated control (C1), biosurfactant-treated (C2), and SDS-treated (C3). After a 24-hour treatment period, oil degradation was quantified using total petroleum hydrocarbon (TPH) analysis via n-hexane extraction. The results demonstrated that no measurable oil degradation was observed in C1. For C2 (Biosurfactant), crude oil degradation reached 1.186 g, indicating effective removal by the bacterial biosurfactant. For C3 (SDS), a slightly higher degradation of 1.512 g was recorded and therefore, C3 served as a positive control (Table 4). The results confirmed the practical applicability of the biosurfactant in facilitating crude-oil removal from marine environments, with its performance approaching that of a commercial surfactant.
Table (4):
Degradation of oil by biosurfactant from B. cereus in-comparison with SDS
No. |
Experiment |
Surfactant |
Oil Degradation (gm) |
|---|---|---|---|
1. |
C1 |
Water (control) |
– |
2. |
C2 |
Biosurfactant |
1.186 |
3. |
C3 |
SDS |
1.512 |
A one-way analysis of variance (ANOVA) was conducted using triplicate values for oil degradation across the treatments (Biosurfactant, SDS, and Control). The analysis revealed a statistically significant difference among the groups (F = 2189.91; P = 2.56 x 10-9; p < 0.001). Post-hoc analysis (Tukey’s HSD) further confirmed that both SDS and the biosurfactant significantly outperformed the control (p < 0.001), and SDS showed significantly higher degradation than the biosurfactant (p = 0.001).
In this study, 21 morphologically distinct bacterial isolates were obtained from oil-polluted marine water samples sourced from Ennore Harbor. Among these, 15 isolates demonstrated the ability to utilize crude oil as the primary carbon source, indicating their potential as HDB. These results are consistent with those of earlier studies that emphasized the widespread occurrence of hydrocarbon-degrading microbes in marine ecosystems affected by oil contamination.16 reported the dominance of hydrocarbonoclastic bacteria such as Alcanivorax and Marinobacter in oil-contaminated marine ecosystems, emphasizing their roles in natural bioremediation processes.
The 15 HDB isolates were further examined for biosurfactant production using multiple assays, including the blue agar plate method, hemolytic activity, oil spreading, drop collapse, and emulsification index (E24). Three isolates (Is4, Is15, and Is18) consistently tested positive in all assays, indicating strong biosurfactant-producing capabilities. The use of multiple screening methods provides a comprehensive assessment of biosurfactant production, as different assays evaluate various properties such as surface activity and emulsification potential. Similar multi-assay approaches have been employed in recent studies to identify potent biosurfactant producers among marine bacterial isolates.17
Under optimized culture conditions, at pH 7.0 and 37 °C with glucose and peptone as carbon and nitrogen sources, respectively, isolate B. cereus Is15 exhibited the highest biosurfactant yield (0.091 g) and crude oil degradation (0.643 g), followed by isolates Is4 and Is18. The correlation between biosurfactant production and hydrocarbon degradation efficiency underscores the importance of biosurfactants in improving the bioavailability of hydrophobic substrates. This observation aligns with the findings of Das and Mukherjee,18 who demonstrated that biosurfactant-producing bacteria exhibit superior hydrocarbon degradation capabilities owing to the improved emulsification and solubilization of oil components.
The close phylogenetic clustering of isolate Is15 with established Bacillus cereus strains highlights its strong evolutionary relatedness to taxa known for biosurfactant production and hydrocarbon degradation. This taxonomic proximity suggests the presence of conserved metabolic capabilities relevant to petroleum bioremediation. B. cereus is well documented for its ability to survive in oil-contaminated environments due to spore formation, enzyme secretion, and surfactant-mediated emulsification of hydrophobicity.19 Its inclusion in oil-degrading consortia across various ecosystems further supports its functional role in bioremediation.20 Thus, the phylogenetic position and ecological traits of Is15 underscore its potential as a bioresource for crude oil degradation.
To enhance the biosurfactant yield and degradation efficiency, various culture parameters were optimized, and the optimal pH for biosurfactant yield was found to be 7.0, with a yield of 0.087 g and oil degradation of 0.644 g. Neutral pH conditions are known to favor microbial growth and metabolic activity. This is consistent with the observations of Mnif et al,4 who reported optimal biosurfactant production by Bacillus subtilis at pH 7. Similarly, B. salmalaya 139SI exhibited the maximum amount of biosurfactant at pH 6.5 and 36 °C.21 These studies suggests that a neutral to slightly alkaline pH favors biosurfactant synthesis, likely because of enhanced microbial growth and enzyme activity in this range.
The maximum biosurfactant yield (0.056 g) and oil degradation (0.481 g) were achieved at 37 °C. Temperature influences the enzymatic activities involved in biosurfactant synthesis, and optimal production at mesophilic temperatures has been reported in several studies.22 observed maximal biosurfactant production by P. aeruginosa at 37 °C. Similarly, the biosurfactant produced by Bacillus aryabhattai ZDY2 demonstrated thermal stability even up to 100 °C, with no substantial alteration in the emulsification index (E24%).23 These findings indicate that moderate temperatures (35-42 °C) are conducive to biosurfactant production, possibly due to optimal enzyme activity and microbial metabolism within this range.
Among the carbon sources tested, glucose resulted in the highest biosurfactant production (0.089 g) and oil degradation (0.589 g). The preference for glucose can be attributed to its ease of assimilation and high energy efficiency. This was also shown by Zhu et al.24 who demonstrated improved biosurfactant production by Bacillus subtilis when cultured with glucose as the sole carbon source. Additionally,25 highlighted glycerol as a promising substrate for biosurfactant production by Bacillus velezensis, indicating that the choice of the carbon source significantly influences the yield. The preference for glucose may be attributed to its ease of assimilation and energy efficiency during microbial metabolism.
Peptone was identified as the most effective nitrogen source, yielding 0.096 g of biosurfactant and 0.724 g of oil. The complex nature of peptone provides a rich supply of amino acids and peptides that support robust microbial growth and metabolite production. This result agrees with the data recorded by Jiang et al.26 who demonstrated that peptone is a more efficient nitrogen source than other nitrogen sources for enhancing biosurfactant synthesis in Pseudomonas aeruginosa. Similarly,27 observed that higher concentrations of NaNO3 promoted increased rhamnolipid production by P. aeruginosa ATCC 9027, suggesting that both the nature and concentration of nitrogen play critical roles in optimizing biosurfactant yield.
Combining the optimal parameters, glucose and peptone at pH 7.0 and 37 °C resulted in the highest biosurfactant yield (0.120 g) and maximum oil degradation (1.084 g) in our study. These findings concur with those of Yaraguppi report,23 who optimized biosurfactant production by Bacillus aryabhattai strain ZDY2 using response surface methodology and identified temperature and carbon sources as significant factors. The synergy of the optimized conditions enhanced biosurfactant production, emphasizing the need for comprehensive parameter optimization in bioprocess development.
GC-MS profiling of the biosurfactant synthesized using Bacillus cereus Is15 indicated its diverse composition, including fatty acid esters, hydrocarbons, and alcohols. Isopropyl myristate (43.97%) and tetradecanoic acid (13.40%) were the most abundant. These compounds are recognized for their ability to lower the surface tension and promote emulsification, which are essential characteristics of effective biosurfactants. Supporting evidence from recent literature includes a study by Atef et al.,28 who reported hexadecanoic acid methyl ester as a key component of the biosurfactant produced by Bacillus cereus AHMNAZ1, indicating its utility in oil recovery. Similarly,29 highlighted the ability of biosurfactants produced by Bacillus cereus to remove crude oil from contaminated soils, reinforcing their potential application in bioremediation.
The presence of long-chain hydrocarbons, such as heptadecane and pentacosane, further supports the hydrophobic interactions necessary for biosurfactant function. These components facilitate micelle formation and enhance the solubilization of hydrophobic pollutants30 showed that biosurfactants from Bacillus cereus isolated from seawater exhibited high emulsification indices and stability across a range of environmental conditions, making them suitable for marine oil-spill bioremediation. Moreover, the detection of compounds, such as 2,4-di-tert-butylphenol, suggests potential antimicrobial properties that could be advantageous for controlling pathogenic microorganisms in contaminated environments.31 observed similar antimicrobial activities for biosurfactants produced by Bacillus sp. MN 243657, indicating a broad application spectrum beyond environmental remediation.
The utilization of organic waste substrates for biosurfactant production, as reported for Bacillus cereus GX7, presents a sustainable and cost-effective approach for converting low-value waste into high-value microbial products. This strategy not only reduces production expenses but also contributes to waste management solutions. Notably, the biosurfactants produced by B. cereus GX7 under these conditions demonstrated superior diesel oil degradation efficiency in seawater, outperforming native microbial populations in remediation trials.32 In summary, the biosurfactant from Bacillus cereus Is15 exhibits a diverse chemical composition with significant potential for environmental and industrial applications. The consistency of our results with those of recent research highlights the potential and adaptability of Bacillus cereus Is15-derived biosurfactants for tackling issues related to environmental contamination.
The efficiency of the biosurfactant produced by Bacillus cereus Is15 was evaluated in a laboratory-based crude oil degradation experiment using 100 mL of seawater artificially contaminated with crude oil. The application of the biosurfactant led to the breakdown of 1.186 g of crude oil, a value comparable to that achieved with the synthetic surfactant SDS (1.512 g). This demonstrates the strong potential of biosurfactants as environmentally friendly substitutes for chemical surfactants in marine oil spill clean-up. These findings agree with the observations of Uzoigwe et al.33 report that highlighted the benefits of microbial biosurfactants, such as lower toxicity, biodegradability, and stability under harsh environmental conditions over their synthetic counterparts. Although SDS demonstrated significantly higher oil degradation compared to the biosurfactant, the biosurfactant produced by Bacillus cereus Is15 also exhibited strong and consistent degradation efficiency, indicating its potential applicability in oil bioremediation. Its performance, although slightly lower than that of SDS, was statistically robust and supports its utility as an effective and eco-friendly alternative.
This study successfully isolated bacteria capable of producing hydrocarbon-degrading biosurfactants from the chronically polluted marine waters of Ennore Harbor and identifying Bacillus cereus Is15 as a potent candidate. Comprehensive phenotypic assays confirmed its robust surface-active properties, and 16S rRNA-based phylogenetic analysis validated its taxonomic identity. Under optimized culture conditions, at pH 7, 37 °C with peptone and glucose as nitrogen and carbon sources, respectively, the isolate exhibited high biosurfactant production (0.120 g) and crude oil degradation (1.084 g), underscoring the importance of environmental parameters in maximizing metabolite yield. GC-MS profiling revealed a chemically diverse biosurfactant composition rich in fatty acid esters and aliphatic hydrocarbons, notably isopropyl myristate and tetradecanoic acid, both of which are known to have emulsifying and surfactant properties. When applied to a simulated marine oil spill system, the biosurfactant achieved an oil removal of 1.186 g, nearly matching the performance of SDS (1.512 g), and validating its operational potential. Collectively, these findings highlight B. cereus Is15 derived biosurfactant as viable, low-toxicity alternatives to synthetic surfactants for the bioremediation of oil-contaminated marine habitats. The ecocompatibility, compositional versatility, and degradation efficacy of biosurfactants make them promising agents for sustainable marine pollution control. Future research should prioritize process scale-up, field trials under real spill conditions, and formulation strategies to facilitate industrial adoption and environmental deployment.
ACKNOWLEDGMENTS
The authors express their gratitude to Chromopark Research Centre, as well as Mr. Vignesh M and Ms. Sasirekha P of Jaya College of Arts and Science, for their valuable support and assistance.
CONFLICT OF INTEREST
The authors declare that there is no conflict of interest.
AUTHORS’ CONTRIBUTION
All authors listed have made a substantial, direct and intellectual contribution to the work, and approved it for publication.
FUNDING
None.
DATA AVAILABILITY
All datasets generated or analyzed during this study are included in the manuscript.
ETHICS STATEMENT
Not applicable.
- Das N, Chandran P. Microbial degradation of petroleum hydrocarbon contaminants: an overview. Biotechnol Res Int. 2011;2011(1):941810.
Crossref - Lv Y, Bao J, Zhu L. A comprehensive review of recent and perspective technologies and challenges for the remediation of oil-contaminated sites. Energy Rep. 2022;8:7976-7988.
Crossref - Jahan R, Bodratti AM, Tsianou M, Alexandridis P. Biosurfactants, natural alternatives to synthetic surfactants: Physicochemical properties and applications. Adv Colloid Interface Sci. 2020;275:102061.
Crossref - Mnif I, Ghribi D. Review lipopeptides biosurfactants: mean classes and new insights for industrial, biomedical, and environmental applications. Peptide Science. 2015;104(3):129-47.
- Udotong IR, Eduok SI, Essien JP, Ita BN. Density of hydrocarbonoclastic bacteria and polycyclic aromatic hydrocarbon accumulation in Iko River mangrove ecosystem, Nigeria. World AcadSciEng Technol. 2008;34
- Tahzibi A, Kamal F, Mazaheri AM. Improved production of rhamnolipids by a Pseudomonas aeruginosa mutant. J Biotechnol. 2004;8(1)25-31.
- Adebajo SO, Akintokun AK, Bolaji SE. Biosurfactants producing bacteria from oil-polluted soil in Abeokuta, Ogun State. Ife J Sci. 2018;20(2):287-97.
Crossref - Rani M, Weadge JT, Jabaji S. Isolation and characterization of biosurfactant-producing bacteria from oil well batteries with antimicrobial activities against food-borne and plant pathogens. Front Microbiol. 2020;11:64.
Crossref - Maneerat S, Phetrong K. Isolation of biosurfactant-producing marine bacteria and characteristics of selected biosurfactant. Songklanakarin J Sci Technol. 2007;29(3):781-91.
- Ahmad Z, Crowley D, Marina N, Jha SK. Estimation of biosurfactant yield produced by Klebsiella sp. FKOD36 bacteria using artificial neural network approach. Measurement. 2016;81:163-73.
Crossref - Zargar AN, Lymperatou A, Skiadas I, Kumar M, Srivastava P. Structural and functional characterization of a novel biosurfactant from Bacillus sp. IITD106. J Hazard Mater. 2022;423(Pt B):127201.
Crossref - Chen L, Cai Y, Zhou G, et al. Rapid Sanger sequencing of the 16S rRNA gene for identification of some common pathogens. PLoS One. 2014;9(2):e88886.
Crossref - Kumar S, Stecher G, Li M, Knyaz C, Tamura K. MEGA X: molecular evolutionary genetics analysis across computing platforms. Mol Biol Evol. 2018;35(6):1547-1549.
Crossref - Sahoo S, Datta S, Biswas D. Optimization of culture conditions for biosurfactant production from Pseudomonas aeruginosa OCD1. J AdvSci Res. 2011;2(03):32-36. https://sciensage.info/index.php/JASR/article/view/40
- Patowary K, Patowary R, Kalita MC, Deka S. Characterization of biosurfactant produced during degradation of hydrocarbons using crude oil as sole source of carbon. Front Microbiol. 2017;8:279.
Crossref - Yakimov MM, Timmis KN, Golyshin PN. Obligate oil-degrading marine bacteria. Curr Opin Biotechnol. 2007;18(3):257-266.
Crossref - Satpute SK, Banpurkar AG, Dhakephalkar PK, Banat IM, Chopade BA. Methods for investigating biosurfactants and bioemulsifiers: a review. Crit Rev Biotechnol. 2010;30(2):127-144.
Crossref - Das K, Mukherjee AK. Crude petroleum-oil biodegradation efficiency of Bacillus subtilis and Pseudomonas aeruginosa strains isolated from a petroleum-oil contaminated soil from North-East India. Bioresour Technol. 2007;98(7):1339-1345.
Crossref - Mnif I, Rajhi H, Bouallegue A, Trabelsi N, Ghribi D. Characterization of lipopeptides biosurfactants produced by a newly isolated strain Bacillus subtilis ZNI5: potential environmental application. J Polym Environ. 2022;30(6):2378-2391.
Crossref - Liu Q, Niu J, Liu Y, Li L, Lv J. Optimization of lipopeptide biosurfactant production by Bacillus licheniformis L20 and performance evaluation of biosurfactant mixed system for enhanced oil recovery. J Pet Sci Eng. 2022;208 (Part D):109678.
Crossref - Dadrasnia A, Ismail S. Biosurfactant production by Bacillus salmalaya for lubricating oil solubilization and biodegradation. Int J Environ Res Public Health. 2015;12(8):9848-9863.
Crossref - Tiwary M, Dubey AK. Characterization of biosurfactant produced by a novel strain of Pseudomonas aeruginosa, isolate ADMT1. J Surfactants Deterg. 2018;21(1):113-25.
Crossref - Yaraguppi DA, Bagewadi ZK, Muddapur UM, Mulla SI. Response surface methodology-based optimization of biosurfactant production from isolated Bacillus aryabhattai strain ZDY2. J Pet Explor Prod Technol. 2020 Aug;10:2483-2498.
Crossref - Zhu Z, Zhang B, Chen B, Cai Q, Lin W. Biosurfactant production by marine-originated bacteria Bacillus subtilis and its application for crude oil removal. Water Air Soil Pollut. 2016;227(9):328.
Crossref - Brito HA, Napp AP, Pereira E, et al. Enhanced low-cost lipopeptide biosurfactant production by Bacillus velezensis from residual glycerin. Bioprocess Biosyst Eng. 2024 Sep;47(9):1555-1570.
Crossref - Jiang M, Wang H, Liu J, et al. Isolation and characterization of biosurfactant-producing bacteria for enhancing oil recovery. Processes. 2024;12(11):2575.
Crossref - Invally K, Ju LK. Increased rhamnolipid concentration and productivity achieved with advanced process design. J SurfactDeterg. 2020;23(6):1043-1053.
Crossref - Atef A, Abo Elsoud MM, Elkhouly HI, Sidkey NM. Surfactin production from Bacillus cereus AHMNAZ1 and its potential applications. J Cell Biotechnol. 2024;10(1):45-74.
Crossref - Gracida J, Corona A, Amaro A, Abreu A, Zamudio E. Washing soil contaminated with crude oil using biosurfactant of halotolerant Bacillus cereus, grown under different conditions. Biologia. 2023;78(8):2195-2202.
Crossref - Durval IJB, Resende AHM, Figueiredo MA, Luna JM, Rufino RD, Sarubbo LA. Studies on biosurfactants produced using Bacillus cereus isolated from seawater with biotechnological potential for marine oil spill bioremediation. J Surfact Deterg. 2019;22(2):349-363.
Crossref - Brinda CM, Ragunathan R, Johney J. Diversity and distribution of potential biosurfactant-producing Bacillus sp MN 243657, GC-MS analysis and its antimicrobial study. Biosci Biotechnol Res Asia. 2023;20(1):271.
Crossref - Zhang Y, Gao J, Li Q, et al. Biosurfactant production by Bacillus cereus GX7 utilizing organic waste and its application in the remediation of hydrocarbon-contaminated environments. World J Microbiol Biotechnol. 2024;40(11):334.
Crossref - Uzoigwe C, Burgess JG, Ennis CJ, Rahman PKSM. Bioemulsifiers are not biosurfactants and require different screening approaches. Front Microbiol. 2015;6:245.
Crossref
© The Author(s) 2025. Open Access. This article is distributed under the terms of the Creative Commons Attribution 4.0 International License which permits unrestricted use, sharing, distribution, and reproduction in any medium, provided you give appropriate credit to the original author(s) and the source, provide a link to the Creative Commons license, and indicate if changes were made.